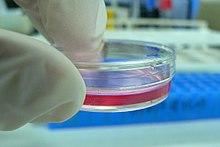

Cell culture is the process by which cells are grown under controlled conditions, generally outside their natural environment. After the cells of interest have been isolated from living tissue, they can subsequently be maintained under carefully controlled conditions. These conditions vary for each cell type, but generally consist of a suitable vessel with a substrate or medium that supplies the essential nutrients (amino acids, carbohydrates, vitamins, minerals), growth factors, hormones, and gases (CO2, O2), and regulates the physio-chemical environment (pH buffer, osmotic pressure, temperature). Most cells require a surface or an artificial substrate (adherent or monolayer culture) whereas others can be grown free floating in culture medium (suspension culture). The lifespan of most cells is genetically determined, but some cell culturing cells have been “transformed” into immortal cells which will reproduce indefinitely if the optimal conditions are provided.
In practice, the term "cell culture" now refers to the culturing of cells derived from multicellular eukaryotes, especially animal cells, in contrast with other types of culture that also grow cells, such as plant tissue culture, fungal culture, and microbiological culture (of microbes). The historical development and methods of cell culture are closely interrelated to those of tissue culture and organ culture. Viral culture is also related, with cells as hosts for the viruses.
The laboratory technique of maintaining live cell lines (a population of cells descended from a single cell and containing the same genetic makeup) separated from their original tissue source became more robust in the middle 20th century.[1][2]
History
The 19th-century English physiologist Sydney Ringer developed salt solutions containing the chlorides of sodium, potassium, calcium and magnesium suitable for maintaining the beating of an isolated animal heart outside the body.[3] In 1885, Wilhelm Roux removed a portion of the medullary plate of an embryonic chicken and maintained it in a warm saline solution for several days, establishing the principle of tissue culture.[4] Ross Granville Harrison, working at Johns Hopkins Medical School and then at Yale University, published results of his experiments from 1907 to 1910, establishing the methodology of tissue culture.[5]
Cell culture techniques were advanced significantly in the 1940s and 1950s to support research in virology. Growing viruses in cell cultures allowed preparation of purified viruses for the manufacture of vaccines. The injectable polio vaccine developed by Jonas Salk was one of the first products mass-produced using cell culture techniques. This vaccine was made possible by the cell culture research of John Franklin Enders, Thomas Huckle Weller, and Frederick Chapman Robbins, who were awarded a Nobel Prize for their discovery of a method of growing the virus in monkey kidney cell cultures.
Concepts in mammalian cell culture
Isolation of cells
Cells can be isolated from tissues for ex vivo culture in several ways. Cells can be easily purified from blood; however, only the white cells are capable of growth in culture. Cells can be isolated from solid tissues by digesting the extracellular matrix using enzymes such as collagenase, trypsin, or pronase, before agitating the tissue to release the cells into suspension.[6][7] Alternatively, pieces of tissue can be placed in growth media, and the cells that grow out are available for culture. This method is known as explant culture.
Cells that are cultured directly from a subject are known as primary cells. With the exception of some derived from tumors, most primary cell cultures have limited lifespan.
An established or immortalized cell line has acquired the ability to proliferate indefinitely either through random mutation or deliberate modification, such as artificial expression of the telomerase gene. Numerous cell lines are well established as representative of particular cell types.
Maintaining cells in culture
For the majority of isolated primary cells, they undergo the process of senescence and stop dividing after a certain number of population doublings while generally retaining their viability (described as the Hayflick limit).
Aside from temperature and gas mixture, the most commonly varied factor in culture systems is the cell growth medium. Recipes for growth media can vary in pH, glucose concentration, growth factors, and the presence of other nutrients. The growth factors used to supplement media are often derived from the serum of animal blood, such as fetal bovine serum (FBS), bovine calf serum, equine serum, and porcine serum. One complication of these blood-derived ingredients is the potential for contamination of the culture with viruses or prions, particularly in medical biotechnology applications. Current practice is to minimize or eliminate the use of these ingredients wherever possible and use human platelet lysate (hPL).[8] This eliminates the worry of cross-species contamination when using FBS with human cells. hPL has emerged as a safe and reliable alternative as a direct replacement for FBS or other animal serum. In addition, chemically defined media can be used to eliminate any serum trace (human or animal), but this cannot always be accomplished with different cell types. Alternative strategies involve sourcing the animal blood from countries with minimum BSE/TSE risk, such as The United States, Australia and New Zealand,[9] and using purified nutrient concentrates derived from serum in place of whole animal serum for cell culture.[10]
Plating density (number of cells per volume of culture medium) plays a critical role for some cell types. For example, a lower plating density makes granulosa cells exhibit estrogen production, while a higher plating density makes them appear as progesterone-producing theca lutein cells.[11]
Cells can be grown either in suspension or adherent cultures. Some cells naturally live in suspension, without being attached to a surface, such as cells that exist in the bloodstream. There are also cell lines that have been modified to be able to survive in suspension cultures so they can be grown to a higher density than adherent conditions would allow. Adherent cells require a surface, such as tissue culture plastic or microcarrier, which may be coated with extracellular matrix (such as collagen and laminin) components to increase adhesion properties and provide other signals needed for growth and differentiation. Most cells derived from solid tissues are adherent. Another type of adherent culture is organotypic culture, which involves growing cells in a three-dimensional (3-D) environment as opposed to two-dimensional culture dishes. This 3D culture system is biochemically and physiologically more similar to in vivo tissue, but is technically challenging to maintain because of many factors (e.g. diffusion).[12]
Components of cell culture media
| Component :) | Function |
|---|---|
| Carbon source (glucose/glutamine) | Source of energy |
| Amino acid | Building blocks of protein |
| Vitamins | Promote cell survival and growth |
| Balanced salt solution | An isotonic mixture of ions to maintain optimum osmotic pressure within the cells and provide essential metal ions to act as cofactors for enzymatic reactions, cell adhesion etc. |
| Phenol red dye | pH indicator. The color of phenol red changes from orange/red at pH 7–7.4 to yellow at acidic (lower) pH and purple at basic (higher) pH. |
| Bicarbonate /HEPES buffer | It is used to maintain a balanced pH in the media |
Typical Growth conditions
| Parameter | |
|---|---|
| Temperature | 37 °C |
| CO2 | 5% |
| Relative Humidity | 95% |
Cell line cross-contamination
Cell line cross-contamination can be a problem for scientists working with cultured cells.[13] Studies suggest anywhere from 15–20% of the time, cells used in experiments have been misidentified or contaminated with another cell line.[14][15][16] Problems with cell line cross-contamination have even been detected in lines from the NCI-60 panel, which are used routinely for drug-screening studies.[17][18] Major cell line repositories, including the American Type Culture Collection (ATCC), the European Collection of Cell Cultures (ECACC) and the German Collection of Microorganisms and Cell Cultures (DSMZ), have received cell line submissions from researchers that were misidentified by them.[17][19] Such contamination poses a problem for the quality of research produced using cell culture lines, and the major repositories are now authenticating all cell line submissions.[20] ATCC uses short tandem repeat (STR) DNA fingerprinting to authenticate its cell lines.[21]
To address this problem of cell line cross-contamination, researchers are encouraged to authenticate their cell lines at an early passage to establish the identity of the cell line. Authentication should be repeated before freezing cell line stocks, every two months during active culturing and before any publication of research data generated using the cell lines. Many methods are used to identify cell lines, including isoenzyme analysis, human lymphocyte antigen (HLA) typing, chromosomal analysis, karyotyping, morphology and STR analysis.[21]
One significant cell-line cross contaminant is the immortal HeLa cell line.
Other technical issues
As cells generally continue to divide in culture, they generally grow to fill the available area or volume. This can generate several issues:
- Nutrient depletion in the growth media
- Changes in pH of the growth media
- Accumulation of apoptotic/necrotic (dead) cells
- Cell-to-cell contact can stimulate cell cycle arrest, causing cells to stop dividing, known as contact inhibition.
- Cell-to-cell contact can stimulate cellular differentiation.
- Genetic and epigenetic alterations, with a natural selection of the altered cells potentially leading to overgrowth of abnormal, culture-adapted cells with decreased differentiation and increased proliferative capacity.[22]
The choice of culture medium might affect the physiological relevance of findings from cell culture experiments due to the differences in the nutrient composition and concentrations.[23] A systematic bias in generated datasets was recently shown for CRISPR and RNAi gene silencing screens,[24] and for metabolic profiling of cancer cell lines.[23] Using a growth medium that better represents the physiological levels of nutrients can improve the physiological relevance of in vitro studies and recently such media types, as Plasmax[25] and Human Plasma Like Medium (HPLM),[26] were developed.
Manipulation of cultured cells
Among the common manipulations carried out on culture cells are media changes, passaging cells, and transfecting cells. These are generally performed using tissue culture methods that rely on aseptic technique. Aseptic technique aims to avoid contamination with bacteria, yeast, or other cell lines. Manipulations are typically carried out in a biosafety cabinet or laminar flow cabinet to exclude contaminating micro-organisms. Antibiotics (e.g. penicillin and streptomycin) and antifungals (e.g.amphotericin B and Antibiotic-Antimycotic solution) can also be added to the growth media.
As cells undergo metabolic processes, acid is produced and the pH decreases. Often, a pH indicator is added to the medium to measure nutrient depletion.
Media changes
In the case of adherent cultures, the media can be removed directly by aspiration, and then is replaced. Media changes in non-adherent cultures involve centrifuging the culture and resuspending the cells in fresh media.
Passaging cells
Passaging (also known as subculture or splitting cells) involves transferring a small number of cells into a new vessel. Cells can be cultured for a longer time if they are split regularly, as it avoids the senescence associated with prolonged high cell density. Suspension cultures are easily passaged with a small amount of culture containing a few cells diluted in a larger volume of fresh media. For adherent cultures, cells first need to be detached; this is commonly done with a mixture of trypsin-EDTA; however, other enzyme mixes are now available for this purpose. A small number of detached cells can then be used to seed a new culture. Some cell cultures, such as RAW cells are mechanically scraped from the surface of their vessel with rubber scrapers.
Transfection and transduction
Another common method for manipulating cells involves the introduction of foreign DNA by transfection. This is often performed to cause cells to express a gene of interest. More recently, the transfection of RNAi constructs have been realized as a convenient mechanism for suppressing the expression of a particular gene/protein. DNA can also be inserted into cells using viruses, in methods referred to as transduction, infection or transformation. Viruses, as parasitic agents, are well suited to introducing DNA into cells, as this is a part of their normal course of reproduction.
Established human cell lines
Cell lines that originate with humans have been somewhat controversial in bioethics, as they may outlive their parent organism and later be used in the discovery of lucrative medical treatments. In the pioneering decision in this area, the Supreme Court of California held in Moore v. Regents of the University of California that human patients have no property rights in cell lines derived from organs removed with their consent.[27]
It is possible to fuse normal cells with an immortalised cell line. This method is used to produce monoclonal antibodies. In brief, lymphocytes isolated from the spleen (or possibly blood) of an immunised animal are combined with an immortal myeloma cell line (B cell lineage) to produce a hybridoma which has the antibody specificity of the primary lymphocyte and the immortality of the myeloma. Selective growth medium (HA or HAT) is used to select against unfused myeloma cells; primary lymphoctyes die quickly in culture and only the fused cells survive. These are screened for production of the required antibody, generally in pools to start with and then after single cloning.
Cell strains
A cell strain is derived either from a primary culture or a cell line by the selection or cloning of cells having specific properties or characteristics which must be defined. Cell strains are cells that have been adapted to culture but, unlike cell lines, have a finite division potential. Non-immortalized cells stop dividing after 40 to 60 population doublings[28] and, after this, they lose their ability to proliferate (a genetically determined event known as senescence).[29]
Applications of cell culture
Mass culture of animal cell lines is fundamental to the manufacture of viral vaccines and other products of biotechnology. Culture of human stem cells is used to expand the number of cells and differentiate the cells into various somatic cell types for transplantation.[30] Stem cell culture is also used to harvest the molecules and exosomes that the stem cells release for the purposes of therapeutic development.[31]
Biological products produced by recombinant DNA (rDNA) technology in animal cell cultures include enzymes, synthetic hormones, immunobiologicals (monoclonal antibodies, interleukins, lymphokines), and anticancer agents. Although many simpler proteins can be produced using rDNA in bacterial cultures, more complex proteins that are glycosylated (carbohydrate-modified) currently must be made in animal cells. An important example of such a complex protein is the hormone erythropoietin. The cost of growing mammalian cell cultures is high, so research is underway to produce such complex proteins in insect cells or in higher plants, use of single embryonic cell and somatic embryos as a source for direct gene transfer via particle bombardment, transit gene expression and confocal microscopy observation is one of its applications. It also offers to confirm single cell origin of somatic embryos and the asymmetry of the first cell division, which starts the process.
Cell culture is also a key technique for cellular agriculture, which aims to provide both new products and new ways of producing existing agricultural products like milk, (cultured) meat, fragrances, and rhino horn from cells and microorganisms. It is therefore considered one means of achieving animal-free agriculture. It is also a central tool for teaching cell biology.[32]
Cell culture in two dimensions
Research in tissue engineering, stem cells and molecular biology primarily involves cultures of cells on flat plastic dishes. This technique is known as two-dimensional (2D) cell culture, and was first developed by Wilhelm Roux who, in 1885, removed a portion of the medullary plate of an embryonic chicken and maintained it in warm saline for several days on a flat glass plate. From the advance of polymer technology arose today's standard plastic dish for 2D cell culture, commonly known as the Petri dish. Julius Richard Petri, a German bacteriologist, is generally credited with this invention while working as an assistant to Robert Koch. Various researchers today also utilize culturing laboratory flasks, conicals, and even disposable bags like those used in single-use bioreactors.
Aside from Petri dishes, scientists have long been growing cells within biologically derived matrices such as collagen or fibrin, and more recently, on synthetic hydrogels such as polyacrylamide or PEG. They do this in order to elicit phenotypes that are not expressed on conventionally rigid substrates. There is growing interest in controlling matrix stiffness,[33] a concept that has led to discoveries in fields such as:
- Stem cell self-renewal[34][35]
- Lineage specification[36]
- Cancer cell phenotype[37][38][39]
- Fibrosis[40][41]
- Hepatocyte function[42][43][44]
- Mechanosensing[45][46][47]
Cell culture in three dimensions
Cell culture in three dimensions has been touted as "Biology's New Dimension".[48] At present, the practice of cell culture remains based on varying combinations of single or multiple cell structures in 2D.[49] Currently, there is an increase in use of 3D cell cultures in research areas including drug discovery, cancer biology, regenerative medicine, nanomaterials assessment and basic life science research.[50][51][52] 3D cell cultures can be grown using a scaffold or matrix, or in a scaffold-free manner. Scaffold based cultures utilize an acellular 3D matrix or a liquid matrix. Scaffold-free methods are normally generated in suspensions.[53] There are a variety of platforms used to facilitate the growth of three-dimensional cellular structures including scaffold systems such as hydrogel matrices[54] and solid scaffolds, and scaffold-free systems such as low-adhesion plates, nanoparticle facilitated magnetic levitation,[55] and hanging drop plates.[56][57]
3D cell culture in scaffolds
Eric Simon, in a 1988 NIH SBIR grant report, showed that electrospinning could be used to produced nano- and submicron-scale polystyrene and polycarbonate fibrous scaffolds specifically intended for use as in vitro cell substrates. This early use of electrospun fibrous lattices for cell culture and tissue engineering showed that various cell types including Human Foreskin Fibroblasts (HFF), transformed Human Carcinoma (HEp-2), and Mink Lung Epithelium (MLE) would adhere to and proliferate upon polycarbonate fibers. It was noted that, as opposed to the flattened morphology typically seen in 2D culture, cells grown on the electrospun fibers exhibited a more histotypic rounded 3-dimensional morphology generally observed in vivo.[58]
3D cell culture in hydrogels
As the natural extracellular matrix (ECM) is important in the survival, proliferation, differentiation and migration of cells, different hydrogel culture matrices mimicking natural ECM structure are seen as potential approaches to in vivo –like cell culturing.[59] Hydrogels are composed of interconnected pores with high water retention, which enables efficient transport of substances such as nutrients and gases. Several different types of hydrogels from natural and synthetic materials are available for 3D cell culture, including animal ECM extract hydrogels, protein hydrogels, peptide hydrogels, polymer hydrogels, and wood-based nanocellulose hydrogel.
3D Cell Culturing by Magnetic Levitation
The 3D Cell Culturing by Magnetic Levitation method (MLM) is the application of growing 3D tissue by inducing cells treated with magnetic nanoparticle assemblies in spatially varying magnetic fields using neodymium magnetic drivers and promoting cell to cell interactions by levitating the cells up to the air/liquid interface of a standard petri dish. The magnetic nanoparticle assemblies consist of magnetic iron oxide nanoparticles, gold nanoparticles, and the polymer polylysine. 3D cell culturing is scalable, with the capability for culturing 500 cells to millions of cells or from single dish to high-throughput low volume systems.
Tissue culture and engineering
Cell culture is a fundamental component of tissue culture and tissue engineering, as it establishes the basics of growing and maintaining cells in vitro. The major application of human cell culture is in stem cell industry, where mesenchymal stem cells can be cultured and cryopreserved for future use. Tissue engineering potentially offers dramatic improvements in low cost medical care for hundreds of thousands of patients annually.
Vaccines
Vaccines for polio, measles, mumps, rubella, and chickenpox are currently made in cell cultures. Due to the H5N1 pandemic threat, research into using cell culture for influenza vaccines is being funded by the United States government. Novel ideas in the field include recombinant DNA-based vaccines, such as one made using human adenovirus (a common cold virus) as a vector,[60][61] and novel adjuvants.[62]
Culture of non-mammalian cells
Besides the culture of well-established immortalised cell lines, cells from primary explants of a plethora of organisms can be cultured for a limited period of time before senescence occurs (see Hayflick's limit). Cultured primary cells have been extensively used in research, as is the case of fish keratocytes in cell migration studies.[63][32][64]
Plant cell culture methods
Plant cell cultures are typically grown as cell suspension cultures in a liquid medium or as callus cultures on a solid medium. The culturing of undifferentiated plant cells and calli requires the proper balance of the plant growth hormones auxin and cytokinin.
Insect cell culture
Cells derived from Drosophila melanogaster (most prominently, Schneider 2 cells) can be used for experiments which may be hard to do on live flies or larvae, such as biochemical studies or studies using siRNA. Cell lines derived from the army worm Spodoptera frugiperda, including Sf9 and Sf21, and from the cabbage looper Trichoplusia ni, High Five cells, are commonly used for expression of recombinant proteins using baculovirus.
Bacterial and yeast culture methods
For bacteria and yeasts, small quantities of cells are usually grown on a solid support that contains nutrients embedded in it, usually a gel such as agar, while large-scale cultures are grown with the cells suspended in a nutrient broth.
Viral culture methods
The culture of viruses requires the culture of cells of mammalian, plant, fungal or bacterial origin as hosts for the growth and replication of the virus. Whole wild type viruses, recombinant viruses or viral products may be generated in cell types other than their natural hosts under the right conditions. Depending on the species of the virus, infection and viral replication may result in host cell lysis and formation of a viral plaque.
Common cell lines
- Human cell lines
- DU145 (prostate cancer)
- H295R (adrenocortical cancer)
- HeLa (cervical cancer)
- KBM-7 (chronic myelogenous leukemia)
- LNCaP (prostate cancer)
- MCF-7 (breast cancer)
- MDA-MB-468 (breast cancer)
- PC3 (prostate cancer)
- SaOS-2 (bone cancer)
- SH-SY5Y (neuroblastoma, cloned from a myeloma)
- T-47D (breast cancer)
- THP-1 (acute myeloid leukemia)
- U87 (glioblastoma)
- National Cancer Institute's 60 cancer cell line panel (NCI60)
- Primate cell lines
- Vero (African green monkey Chlorocebus kidney epithelial cell line)
- Mouse cell lines
- MC3T3 (embryonic calvarium)
- Rat tumor cell lines
- GH3 (pituitary tumor)
- PC12 (pheochromocytoma)
- Plant cell lines
- Tobacco BY-2 cells (kept as cell suspension culture, they are model system of plant cell)
- Other species cell lines
- Dog MDCK kidney epithelial
- Xenopus A6 kidney epithelial
- Zebrafish AB9
List of cell lines
| Cell line | Meaning | Organism | Origin tissue | Morphology | Links |
|---|---|---|---|---|---|
| 3T3-L1 | "3-day transfer, inoculum 3 x 10^5 cells" | Mouse | Embryo | Fibroblast | ECACC Cellosaurus |
| 4T1 | Mouse | Mammary gland | ATCC Cellosaurus | ||
| 9L | Rat | Brain | Glioblastoma | ECACC Cellosaurus | |
| A172 | Human | Brain | Glioblastoma | ECACC Cellosaurus | |
| A20 | Mouse | B lymphoma | B lymphocyte | Cellosaurus | |
| A253 | Human | Submandibular duct | Head and neck carcinoma | ATCC Cellosaurus | |
| A2780 | Human | Ovary | Ovarian carcinoma | ECACC Cellosaurus | |
| A2780ADR | Human | Ovary | Adriamycin-resistant derivative of A2780 | ECACC Cellosaurus | |
| A2780cis | Human | Ovary | Cisplatin-resistant derivative of A2780 | ECACC Cellosaurus | |
| A431 | Human | Skin epithelium | Squamous cell carcinoma | ECACC Cellosaurus | |
| A549 | Human | Lung | Lung carcinoma | ECACC Cellosaurus | |
| AB9 | Zebrafish | Fin | Fibroblast | ATCC Cellosaurus | |
| AHL-1 | Armenian Hamster Lung-1 | Hamster | Lung | ECACC Cellosaurus | |
| ALC | Mouse | Bone marrow | Stroma | PMID 2435412[65] Cellosaurus | |
| B16 | Mouse | Melanoma | ECACC Cellosaurus | ||
| B35 | Rat | Neuroblastoma | ATCC Cellosaurus | ||
| BCP-1 | Human | PBMC | HIV+ primary effusion lymphoma | ATCC Cellosaurus | |
| BEAS-2B | Bronchial epithelium + Adenovirus 12-SV40 virus hybrid (Ad12SV40) | Human | Lung | Epithelial | ECACC Cellosaurus |
| bEnd.3 | Brain Endothelial 3 | Mouse | Brain/cerebral cortex | Endothelium | Cellosaurus |
| BHK-21 | Baby Hamster Kidney-21 | Hamster | Kidney | Fibroblast | ECACC Cellosaurus |
| BOSC23 | Packaging cell line derived from HEK 293 | Human | Kidney (embryonic) | Epithelium | Cellosaurus |
| BT-20 | Breast Tumor-20 | Human | Breast epithelium | Breast carcinoma | ATCC Cellosaurus |
| BxPC-3 | Biopsy xenograft of Pancreatic Carcinoma line 3 | Human | Pancreatic adenocarcinoma | Epithelial | ECACC Cellosaurus |
| C2C12 | Mouse | Myoblast | ECACC Cellosaurus | ||
| C3H-10T1/2 | Mouse | Embryonic mesenchymal cell line | ECACC Cellosaurus | ||
| C6 | Rat | Brain astrocyte | Glioma | ECACC Cellosaurus | |
| C6/36 | Insect - Asian tiger mosquito | Larval tissue | ECACC Cellosaurus | ||
| Caco-2 | Human | Colon | Colorectal carcinoma | ECACC Cellosaurus | |
| Cal-27 | Human | Tongue | Squamous cell carcinoma | ATCC Cellosaurus | |
| Calu-3 | Human | Lung | Adenocarcinoma | ATCC Cellosaurus | |
| CGR8 | Mouse | Embryonic stem cells | ECACC Cellosaurus | ||
| CHO | Chinese Hamster Ovary | Hamster | Ovary | Epithelium | ECACC Cellosaurus |
| CML T1 | Chronic myeloid leukemia T lymphocyte 1 | Human | CML acute phase | T cell leukemia | DSMZ Cellosaurus |
| CMT12 | Canine Mammary Tumor 12 | Dog | Mammary gland | Epithelium | Cellosaurus |
| COR-L23 | Human | Lung | Lung carcinoma | ECACC Cellosaurus | |
| COR-L23/5010 | Human | Lung | Lung carcinoma | ECACC Cellosaurus | |
| COR-L23/CPR | Human | Lung | Lung carcinoma | ECACC Cellosaurus | |
| COR-L23/R23- | Human | Lung | Lung carcinoma | ECACC Cellosaurus | |
| COS-7 | Cercopithecus aethiops, origin-defective SV-40 | Old World monkey - Cercopithecus aethiops (Chlorocebus) | Kidney | Fibroblast | ECACC Cellosaurus |
| COV-434 | Human | Ovary | Ovarian granulosa cell carcinoma | PMID 8436435[66] ECACC Cellosaurus | |
| CT26 | Mouse | Colon | Colorectal carcinoma | Cellosaurus | |
| D17 | Dog | Lung metastasis | Osteosarcoma | ATCC Cellosaurus | |
| DAOY | Human | Brain | Medulloblastoma | ATCC Cellosaurus | |
| DH82 | Dog | Histiocytosis | Monocyte/macrophage | ECACC Cellosaurus | |
| DU145 | Human | Androgen insensitive prostate carcinoma | ATCC Cellosaurus | ||
| DuCaP | Dura mater cancer of the Prostate | Human | Metastatic prostate carcinoma | Epithelial | PMID 11317521[67] Cellosaurus |
| E14Tg2a | Mouse | Embryonic stem cells | ECACC Cellosaurus | ||
| EL4 | Mouse | T cell leukemia | ECACC Cellosaurus | ||
| EM-2 | Human | CML blast crisis | Ph+ CML line | DSMZ Cellosaurus | |
| EM-3 | Human | CML blast crisis | Ph+ CML line | DSMZ Cellosaurus | |
| EMT6/AR1 | Mouse | Mammary gland | Epithelial-like | ECACC Cellosaurus | |
| EMT6/AR10.0 | Mouse | Mammary gland | Epithelial-like | ECACC Cellosaurus | |
| FM3 | Human | Lymph node metastasis | Melanoma | ECACC Cellosaurus | |
| GL261 | Glioma 261 | Mouse | Brain | Glioma | Cellosaurus |
| H1299 | Human | Lung | Lung carcinoma | ATCC Cellosaurus | |
| HaCaT | Human | Skin | Keratinocyte | CLS Cellosaurus | |
| HCA2 | Human | Colon | Adenocarcinoma | ECACC Cellosaurus | |
| HEK 293 | Human Embryonic Kidney 293 | Human | Kidney (embryonic) | Epithelium | ECACC Cellosaurus |
| HEK 293T | HEK 293 derivative | Human | Kidney (embryonic) | Epithelium | ECACC Cellosaurus |
| HeLa | "Henrietta Lacks" | Human | Cervix epithelium | Cervical carcinoma | ECACC Cellosaurus |
| Hepa1c1c7 | Clone 7 of clone 1 hepatoma line 1 | Mouse | Hepatoma | Epithelial | ECACC Cellosaurus |
| Hep G2 | Human | Liver | Hepatoblastoma | ECACC Cellosaurus | |
| High Five | Insect (moth) - Trichoplusia ni | Ovary | Cellosaurus | ||
| HL-60 | Human Leukemia-60 | Human | Blood | Myeloblast | ECACC Cellosaurus |
| HT-1080 | Human | Fibrosarcoma | ECACC Cellosaurus | ||
| HT-29 | Human | Colon epithelium | Adenocarcinoma | ECACC Cellosaurus | |
| J558L | Mouse | Myeloma | B lymphocyte cell | ECACC Cellosaurus | |
| Jurkat | Human | White blood cells | T cell leukemia | ECACC Cellosaurus | |
| JY | Human | Lymphoblastoid | EBV-transformed B cell | ECACC Cellosaurus | |
| K562 | Human | Lymphoblastoid | CML blast crisis | ECACC Cellosaurus | |
| KBM-7 | Human | Lymphoblastoid | CML blast crisis | Cellosaurus | |
| KCL-22 | Human | Lymphoblastoid | CML | DSMZ Cellosaurus | |
| KG1 | Human | Lymphoblastoid | AML | ECACC Cellosaurus | |
| Ku812 | Human | Lymphoblastoid | Erythroleukemia | ECACC Cellosaurus | |
| KYO-1 | Kyoto-1 | Human | Lymphoblastoid | CML | DSMZ Cellosaurus |
| L1210 | Mouse | Lymphocytic leukemia | Ascitic fluid | ECACC Cellosaurus | |
| L243 | Mouse | Hybridoma | Secretes L243 mAb (against HLA-DR) | ATCC Cellosaurus | |
| LNCaP | Lymph Node Cancer of the Prostate | Human | Prostatic adenocarcinoma | Epithelial | ECACC Cellosaurus |
| MA-104 | Microbiological Associates-104 | African Green Monkey | Kidney | Epithelial | Cellosaurus |
| MA2.1 | Mouse | Hybridoma | Secretes MA2.1 mAb (against HLA-A2 and HLA-B17) | ATCC Cellosaurus | |
| Ma-Mel 1, 2, 3....48 | Human | Skin | A range of melanoma cell lines | ECACC Cellosaurus | |
| MC-38 | Mouse Colon-38 | Mouse | Colon | Adenocarcinoma | Cellosaurus |
| MCF-7 | Michigan Cancer Foundation-7 | Human | Breast | Invasive breast ductal carcinoma ER+, PR+ | ECACC Cellosaurus |
| MCF-10A | Michigan Cancer Foundation-10A | Human | Breast epithelium | ATCC Cellosaurus | |
| MDA-MB-157 | M.D. Anderson - Metastatic Breast-157 | Human | Pleural effusion metastasis | Breast carcinoma | ECACC Cellosaurus |
| MDA-MB-231 | M.D. Anderson - Metastatic Breast-231 | Human | Pleural effusion metastasis | Breast carcinoma | ECACC Cellosaurus |
| MDA-MB-361 | M.D. Anderson - Metastatic Breast-361 | Human | Melanoma (contaminated by M14) | ECACC Cellosaurus | |
| MDA-MB-468 | M.D. Anderson - Metastatic Breast-468 | Human | Pleural effusion metastasis | Breast carcinoma | ATCC Cellosaurus |
| MDCK II | Madin Darby Canine Kidney II | Dog | Kidney | Epithelium | ECACC Cellosaurus |
| MG63 | Human | Bone | Osteosarcoma | ECACC Cellosaurus | |
| MIA PaCa-2 | Human | Prostate | Pancreatic Carcinoma | ATCC Cellosaurus | |
| MOR/0.2R | Human | Lung | Lung carcinoma | ECACC Cellosaurus | |
| Mono-Mac-6 | Human | White blood cells | Myeloid metaplasic AML | DSMZ Cellosaurus | |
| MRC-5 | Medical Research Council cell strain 5 | Human | Lung (fetal) | Fibroblast | ECACC Cellosaurus |
| MTD-1A | Mouse | Epithelium | Cellosaurus | ||
| MyEnd | Myocardial Endothelial | Mouse | Endothelium | Cellosaurus | |
| NCI-H69 | Human | Lung | Lung carcinoma | ECACC Cellosaurus | |
| NCI-H69/CPR | Human | Lung | Lung carcinoma | ECACC Cellosaurus | |
| NCI-H69/LX10 | Human | Lung | Lung carcinoma | ECACC Cellosaurus | |
| NCI-H69/LX20 | Human | Lung | Lung carcinoma | ECACC Cellosaurus | |
| NCI-H69/LX4 | Human | Lung | Lung carcinoma | ECACC Cellosaurus | |
| Neuro-2a | Mouse | Nerve/neuroblastoma | Neuronal stem cells | ECACC Cellosaurus | |
| NIH-3T3 | NIH, 3-day transfer, inoculum 3 x 105 cells | Mouse | Embryo | Fibroblast | ECACC Cellosaurus |
| NALM-1 | Human | Peripheral blood | Blast-crisis CML | ATCC Cellosaurus | |
| NK-92 | Human | Leukemia/lymphoma | ATCC Cellosaurus | ||
| NTERA-2 | Human | Lung metastasis | Embryonal carcinoma | ECACC Cellosaurus | |
| NW-145 | Human | Skin | Melanoma | ESTDAB Cellosaurus | |
| OK | Opossum Kidney | Virginia opossum - Didelphis virginiana | Kidney | ECACC Cellosaurus | |
| OPCN / OPCT cell lines | Human | Prostate | Range of prostate tumour lines | Cellosaurus | |
| P3X63Ag8 | Mouse | Myeloma | ECACC Cellosaurus | ||
| PANC-1 | Human | Duct | Epithelioid Carcinoma | ATCC Cellosaurus | |
| PC12 | Rat | Adrenal medulla | Pheochromocytoma | ECACC Cellosaurus | |
| PC-3 | Prostate Cancer-3 | Human | Bone metastasis | Prostate carcinoma | ECACC Cellosaurus |
| Peer | Human | T cell leukemia | DSMZ Cellosaurus | ||
| PNT1A | Human | Prostate | SV40-transformed tumour line | ECACC Cellosaurus | |
| PNT2 | Human | Prostate | SV40-transformed tumour line | ECACC Cellosaurus | |
| Pt K2 | The second cell line derived from Potorous tridactylis | Long-nosed potoroo - Potorous tridactylus | Kidney | Epithelial | ECACC Cellosaurus |
| Raji | Human | B lymphoma | Lymphoblast-like | ECACC Cellosaurus | |
| RBL-1 | Rat Basophilic Leukemia-1 | Rat | Leukemia | Basophil cell | ECACC Cellosaurus |
| RenCa | Renal Carcinoma | Mouse | Kidney | Renal carcinoma | ATCC Cellosaurus |
| RIN-5F | Mouse | Pancreas | ECACC Cellosaurus | ||
| RMA-S | Mouse | T cell tumour | Cellosaurus | ||
| S2 | Schneider 2 | Insect - Drosophila melanogaster | Late stage (20–24 hours old) embryos | ATCC Cellosaurus | |
| SaOS-2 | Sarcoma OSteogenic-2 | Human | Bone | Osteosarcoma | ECACC Cellosaurus |
| Sf21 | Spodoptera frugiperda 21 | Insect (moth) - Spodoptera frugiperda | Ovary | ECACC Cellosaurus | |
| Sf9 | Spodoptera frugiperda 9 | Insect (moth) - Spodoptera frugiperda | Ovary | ECACC Cellosaurus | |
| SH-SY5Y | Human | Bone marrow metastasis | Neuroblastoma | ECACC Cellosaurus | |
| SiHa | Human | Cervix epithelium | Cervical carcinoma | ATCC Cellosaurus | |
| SK-BR-3 | Sloan-Kettering Breast cancer 3 | Human | Breast | Breast carcinoma | DSMZ Cellosaurus |
| SK-OV-3 | Sloan-Kettering Ovarian cancer 3 | Human | Ovary | Ovarian carcinoma | ECACC Cellosaurus |
| SK-N-SH | Human | Brain | Epithelial | ATCC Cellosaurus | |
| T2 | Human | T cell leukemia/B cell line hybridoma | ATCC Cellosaurus | ||
| T-47D | Human | Breast | Breast ductal carcinoma | ECACC Cellosaurus | |
| T84 | Human | Lung metastasis | Colorectal carcinoma | ECACC Cellosaurus | |
| T98G | Human | Glioblastoma-astrocytoma | Epithelium | ECACC Cellosaurus | |
| THP-1 | Human | Monocyte | Acute monocytic leukemia | ECACC Cellosaurus | |
| U2OS | Human | Osteosarcoma | Epithelial | ECACC Cellosaurus | |
| U373 | Human | Glioblastoma-astrocytoma | Epithelium | ECACC Cellosaurus | |
| U87 | Human | Glioblastoma-astrocytoma | Epithelial-like | ECACC Cellosaurus | |
| U937 | Human | Leukemic monocytic lymphoma | ECACC Cellosaurus | ||
| VCaP | Vertebral Cancer of the Prostate | Human | Vertebra metastasis | Prostate carcinoma | ECACC Cellosaurus |
| Vero | From Esperanto: verda (green, for green monkey) reno (kidney) | African green monkey - Chlorocebus sabaeus | Kidney epithelium | ECACC Cellosaurus | |
| VG-1 | Human | Primary effusion lymphoma | Cellosaurus | ||
| WM39 | Human | Skin | Melanoma | ESTDAB Cellosaurus | |
| WT-49 | Human | Lymphoblastoid | ECACC Cellosaurus | ||
| YAC-1 | Mouse | Lymphoma | ECACC Cellosaurus | ||
| YAR | Human | Lymphoblastoid | EBV-transformed B cell | Human Immunology[68] ECACC Cellosaurus |
See also
- Biological immortality
- Cell culture assays
- Electric cell-substrate impedance sensing
- List of contaminated cell lines
- List of NCI-60 Cell Lines
- List of breast cancer cell lines
References and notes
- ^ "Some landmarks in the development of tissue and cell culture". Retrieved 2006-04-19.
- ^ "Cell Culture". Retrieved 2006-04-19.
- ^ "Whonamedit - Ringer's solution". whonamedit.com. Retrieved 2014-06-09.
- ^ "Animals and alternatives in testing". Archived from the original on 2006-02-25. Retrieved 2006-04-19.
- ^ Schiff J (February 2002). "An unsung hero of medical research". Yale Alumni Magazine. Retrieved 2006-04-19.
- ^ Voigt N, Pearman CM, Dobrev D, Dibb KM (September 2015). "Methods for isolating atrial cells from large mammals and humans". Journal of Molecular and Cellular Cardiology. 86: 187–98. doi:10.1016/j.yjmcc.2015.07.006. PMID 26186893.
- ^ Louch WE, Sheehan KA, Wolska BM (September 2011). "Methods in cardiomyocyte isolation, culture, and gene transfer". Journal of Molecular and Cellular Cardiology. 51 (3): 288–98. doi:10.1016/j.yjmcc.2011.06.012. PMC 3164875. PMID 21723873.
- ^ Hemeda, H., Giebel, B., Wagner, W. (16Feb2014) Evaluation of human platelet lysate versus fetal bovine serum for culture of mesenchymal stromal cells Cytotherapy p170-180 issue 2 doi.10.1016
- ^ "Post - Blog | Boval BioSolutions, LLC". bovalco.com. Retrieved 2014-12-02.
- ^ "LipiMAX purified lipoprotein solution from bovine serum". Selborne Biological Services. 2006. Retrieved 2010-02-02.
- ^ Portela VM, Zamberlam G, Price CA (April 2010). "Cell plating density alters the ratio of estrogenic to progestagenic enzyme gene expression in cultured granulosa cells". Fertility and Sterility. 93 (6): 2050–5. doi:10.1016/j.fertnstert.2009.01.151. PMID 19324349.
- ^ Humpel C (October 2015). "Organotypic brain slice cultures: A review". Neuroscience. 305: 86–98. doi:10.1016/j.neuroscience.2015.07.086. PMC 4699268. PMID 26254240.
- ^ Neimark J (February 2015). "Line of attack". Science. 347 (6225): 938–40. doi:10.1126/science.347.6225.938. PMID 25722392.
- ^ Drexler HG, Dirks WG, MacLeod RA (October 1999). "False human hematopoietic cell lines: cross-contaminations and misinterpretations". Leukemia. 13 (10): 1601–7. doi:10.1038/sj.leu.2401510. PMID 10516762.
- ^ Drexler HG, MacLeod RA, Dirks WG (December 2001). "Cross-contamination: HS-Sultan is not a myeloma but a Burkitt lymphoma cell line". Blood. 98 (12): 3495–6. doi:10.1182/blood.V98.12.3495. PMID 11732505.
- ^ Cabrera CM, Cobo F, Nieto A, Cortés JL, Montes RM, Catalina P, Concha A (June 2006). "Identity tests: determination of cell line cross-contamination". Cytotechnology. 51 (2): 45–50. doi:10.1007/s10616-006-9013-8. PMC 3449683. PMID 19002894.
- ^ a b Chatterjee R (February 2007). "Cell biology. Cases of mistaken identity". Science. 315 (5814): 928–31. doi:10.1126/science.315.5814.928. PMID 17303729. S2CID 13255156.
- ^ Liscovitch M, Ravid D (January 2007). "A case study in misidentification of cancer cell lines: MCF-7/AdrR cells (re-designated NCI/ADR-RES) are derived from OVCAR-8 human ovarian carcinoma cells". Cancer Letters. 245 (1–2): 350–2. doi:10.1016/j.canlet.2006.01.013. PMID 16504380.
- ^ MacLeod RA, Dirks WG, Matsuo Y, Kaufmann M, Milch H, Drexler HG (November 1999). "Widespread intraspecies cross-contamination of human tumor cell lines arising at source". International Journal of Cancer. 83 (4): 555–63. doi:10.1002/(SICI)1097-0215(19991112)83:4<555::AID-IJC19>3.0.CO;2-2. PMID 10508494.
- ^ Masters JR (April 2002). "HeLa cells 50 years on: the good, the bad and the ugly". Nature Reviews. Cancer. 2 (4): 315–9. doi:10.1038/nrc775. PMID 12001993. S2CID 991019.
- ^ a b Dunham J, Guthmiller P (2008). "Doing good science: Authenticating cell line identity" (PDF). Cell Notes. 22: 15–17. Archived from the original (PDF) on 2008-10-28. Retrieved 2008-10-28.
- ^ Nguyen HT, Geens M, Spits C (2012). "Genetic and epigenetic instability in human pluripotent stem cells". Human Reproduction Update. 19 (2): 187–205. doi:10.1093/humupd/dms048. PMID 23223511.
- ^ a b Lagziel S, GottliebE, Shlomi T (2020). "Mind your media". Nature Metabolism. doi:10.1038/s42255-020-00299-y.
- ^ Lagziel S, Lee WD, Shlomi T (2019). "Inferring cancer dependencies on metabolic genes from large-scale genetic screens". BMC Biol. 17 (1): 37. doi:10.1186/s12915-019-0654-4. PMC 6489231. PMID 31039782.
- ^ Vande Voorde J, Ackermann T, Pfetzer N, Sumpton D, Mackay G, Kalna G; et al. (2019). "Improving the metabolic fidelity of cancer models with a physiological cell culture medium". Sci Adv. 5 (1): eaau7314. doi:10.1126/sciadv.aau7314. PMC 6314821. PMID 30613774.
- ^ Cantor JR, Abu-Remaileh M, Kanarek N, Freinkman E, Gao X, Louissaint A; et al. (2017). "Physiologic Medium Rewires Cellular Metabolism and Reveals Uric Acid as an Endogenous Inhibitor of UMP Synthase". Cell. 169 (2): 258-272.e17. doi:10.1016/j.cell.2017.03.023. PMC 5421364. PMID 28388410.
- ^ "Moore v. Regents of University of California (1990) 51 C3d 120". Online.ceb.com. Retrieved 2012-01-27.
- ^ Hayflick L (September 1998). "A brief history of the mortality and immortality of cultured cells". The Keio Journal of Medicine. 3. 47 (3): 174–82. doi:10.2302/kjm.47.174. PMID 9785764.
- ^ "Worthington tissue guide". Retrieved 2013-04-30.
- ^ Qian L, Saltzman WM (2004). "Improving the expansion and neuronal differentiation of mesenchymal stem cells through culture surface modification". Biomaterials. 25 (7–8): 1331–7. doi:10.1016/j.biomaterials.2003.08.013. PMID 14643607.
- ^ Maguire G (May 2016). "Therapeutics from Adult Stem Cells and the Hype Curve". ACS Medicinal Chemistry Letters. 7 (5): 441–3. doi:10.1021/acsmedchemlett.6b00125. PMC 4867479. PMID 27190588.
- ^ a b Prieto D, Aparicio G, Sotelo-Silveira JR (November 2017). "Cell migration analysis: A low-cost laboratory experiment for cell and developmental biology courses using keratocytes from fish scales". Biochemistry and Molecular Biology Education. 45 (6): 475–482. doi:10.1002/bmb.21071. PMID 28627731.
- ^ Discher DE, Janmey P, Wang YL (November 2005). "Tissue cells feel and respond to the stiffness of their substrate". Science. 310 (5751): 1139–43. Bibcode:2005Sci...310.1139D. CiteSeerX 10.1.1.318.690. doi:10.1126/science.1116995. PMID 16293750. S2CID 9036803.
- ^ Gilbert PM, Havenstrite KL, Magnusson KE, Sacco A, Leonardi NA, Kraft P, et al. (August 2010). "Substrate elasticity regulates skeletal muscle stem cell self-renewal in culture". Science. 329 (5995): 1078–81. Bibcode:2010Sci...329.1078G. doi:10.1126/science.1191035. PMC 2929271. PMID 20647425.
- ^ Chowdhury F, Li Y, Poh YC, Yokohama-Tamaki T, Wang N, Tanaka TS (December 2010). Zhou Z (ed.). "Soft substrates promote homogeneous self-renewal of embryonic stem cells via downregulating cell-matrix tractions". PLOS ONE. 5 (12): e15655. Bibcode:2010PLoSO...515655C. doi:10.1371/journal.pone.0015655. PMC 3001487. PMID 21179449.
- ^ Engler AJ, Sen S, Sweeney HL, Discher DE (August 2006). "Matrix elasticity directs stem cell lineage specification". Cell. 126 (4): 677–89. doi:10.1016/j.cell.2006.06.044. PMID 16923388.
- ^ Paszek MJ, Zahir N, Johnson KR, Lakins JN, Rozenberg GI, Gefen A, et al. (September 2005). "Tensional homeostasis and the malignant phenotype". Cancer Cell. 8 (3): 241–54. doi:10.1016/j.ccr.2005.08.010. PMID 16169468.
- ^ Levental KR, Yu H, Kass L, Lakins JN, Egeblad M, Erler JT, et al. (November 2009). "Matrix crosslinking forces tumor progression by enhancing integrin signaling". Cell. 139 (5): 891–906. doi:10.1016/j.cell.2009.10.027. PMC 2788004. PMID 19931152.
- ^ Tilghman RW, Cowan CR, Mih JD, Koryakina Y, Gioeli D, Slack-Davis JK, et al. (September 2010). Hotchin NA (ed.). "Matrix rigidity regulates cancer cell growth and cellular phenotype". PLOS ONE. 5 (9): e12905. Bibcode:2010PLoSO...512905T. doi:10.1371/journal.pone.0012905. PMC 2944843. PMID 20886123.
- ^ Liu F, Mih JD, Shea BS, Kho AT, Sharif AS, Tager AM, Tschumperlin DJ (August 2010). "Feedback amplification of fibrosis through matrix stiffening and COX-2 suppression". The Journal of Cell Biology. 190 (4): 693–706. doi:10.1083/jcb.201004082. PMC 2928007. PMID 20733059.
- ^ Wipff PJ, Rifkin DB, Meister JJ, Hinz B (December 2007). "Myofibroblast contraction activates latent TGF-beta1 from the extracellular matrix". The Journal of Cell Biology. 179 (6): 1311–23. doi:10.1083/jcb.200704042. PMC 2140013. PMID 18086923.
- ^ Georges PC, Hui JJ, Gombos Z, McCormick ME, Wang AY, Uemura M, et al. (December 2007). "Increased stiffness of the rat liver precedes matrix deposition: implications for fibrosis". American Journal of Physiology. Gastrointestinal and Liver Physiology. 293 (6): G1147–54. doi:10.1152/ajpgi.00032.2007. PMID 17932231. S2CID 201357.
- ^ Li L, Sharma N, Chippada U, Jiang X, Schloss R, Yarmush ML, Langrana NA (May 2008). "Functional modulation of ES-derived hepatocyte lineage cells via substrate compliance alteration". Annals of Biomedical Engineering. 36 (5): 865–76. doi:10.1007/s10439-008-9458-3. PMID 18266108. S2CID 21773886.
- ^ Semler EJ, Lancin PA, Dasgupta A, Moghe PV (February 2005). "Engineering hepatocellular morphogenesis and function via ligand-presenting hydrogels with graded mechanical compliance". Biotechnology and Bioengineering. 89 (3): 296–307. doi:10.1002/bit.20328. PMID 15744840.
- ^ Friedland JC, Lee MH, Boettiger D (January 2009). "Mechanically activated integrin switch controls alpha5beta1 function". Science. 323 (5914): 642–4. doi:10.1126/science.1168441. PMID 19179533. S2CID 206517419.
- ^ Chan CE, Odde DJ (December 2008). "Traction dynamics of filopodia on compliant substrates". Science. 322 (5908): 1687–91. Bibcode:2008Sci...322.1687C. doi:10.1126/science.1163595. PMID 19074349. S2CID 28568350.
- ^ Dupont S, Morsut L, Aragona M, Enzo E, Giulitti S, Cordenonsi M, et al. (June 2011). "Role of YAP/TAZ in mechanotransduction". Nature. 474 (7350): 179–83. doi:10.1038/nature10137. hdl:11380/673649. PMID 21654799. S2CID 205225137.
- ^ "drug discovery@nature.com". Nature.com. Retrieved 2013-03-26.
- ^ Duell BL, Cripps AW, Schembri MA, Ulett GC (2011). "Epithelial cell coculture models for studying infectious diseases: benefits and limitations". Journal of Biomedicine & Biotechnology. 2011: 852419. doi:10.1155/2011/852419. PMC 3189631. PMID 22007147.
- ^ Barrila J, Radtke AL, Crabbé A, Sarker SF, Herbst-Kralovetz MM, Ott CM, Nickerson CA (November 2010). "Organotypic 3D cell culture models: using the rotating wall vessel to study host-pathogen interactions". Nature Reviews. Microbiology. 8 (11): 791–801. doi:10.1038/nrmicro2423. PMID 20948552. S2CID 6925183.
- ^ Mapanao, Ana Katrina; Voliani, Valerio (June 2020). "Three-dimensional tumor models: Promoting breakthroughs in nanotheranostics translational research". Applied Materials Today. 19: 100552. doi:10.1016/j.apmt.2019.100552.
- ^ Cassano, Domenico; Santi, Melissa; D’Autilia, Francesca; Mapanao, Ana Katrina; Luin, Stefano; Voliani, Valerio (2019). "Photothermal effect by NIR-responsive excretable ultrasmall-in-nano architectures". Materials Horizons. 6 (3): 531–537. doi:10.1039/C9MH00096H. ISSN 2051-6347.
- ^ Edmondson R, Broglie JJ, Adcock AF, Yang L (May 2014). "Three-dimensional cell culture systems and their applications in drug discovery and cell-based biosensors". Assay and Drug Development Technologies. 12 (4): 207–18. doi:10.1089/adt.2014.573. PMC 4026212. PMID 24831787.
- ^ Bhattacharya M, Malinen MM, Lauren P, Lou YR, Kuisma SW, Kanninen L, et al. (December 2012). "Nanofibrillar cellulose hydrogel promotes three-dimensional liver cell culture". Journal of Controlled Release. 164 (3): 291–8. doi:10.1016/j.jconrel.2012.06.039. PMID 22776290.
- ^ DeRosa MC, Monreal C, Schnitzer M, Walsh R, Sultan Y (February 2010). "Nanotechnology in fertilizers". Nature Nanotechnology. 5 (2): 91. Bibcode:2010NatNa...5...91D. doi:10.1038/nnano.2010.2. PMID 20130583.
- ^ Hsiao AY, Tung YC, Qu X, Patel LR, Pienta KJ, Takayama S (May 2012). "384 hanging drop arrays give excellent Z-factors and allow versatile formation of co-culture spheroids". Biotechnology and Bioengineering. 109 (5): 1293–304. doi:10.1002/bit.24399. PMC 3306496. PMID 22161651.
- ^ Mapanao AK, Santi M, Faraci P, Cappello V, Cassano D, Voliani V (September 2018). "Endogenously Triggerable Ultrasmall-in-Nano Architectures: Targeting Assessment on 3D Pancreatic Carcinoma Spheroids". ACS Omega. 3 (9): 11796–11801. doi:10.1021/acsomega.8b01719. PMC 6173554. PMID 30320273.
- ^ Simon EM (1988). "NIH Phase I Final Report: Fibrous Substrates for Cell Culture (R3RR03544A) (PDF Download Available)". ResearchGate. Retrieved 2017-05-22.
- ^ Tibbitt MW, Anseth KS (July 2009). "Hydrogels as extracellular matrix mimics for 3D cell culture". Biotechnology and Bioengineering. 103 (4): 655–63. doi:10.1002/bit.22361. PMC 2997742. PMID 19472329.
- ^ "Quickie Bird Flu Vaccine Created". Wired. Wired.com. Reuters. 2006-01-26. Retrieved 2010-01-31.
- ^ Gao W, Soloff AC, Lu X, Montecalvo A, Nguyen DC, Matsuoka Y, et al. (February 2006). "Protection of mice and poultry from lethal H5N1 avian influenza virus through adenovirus-based immunization". Journal of Virology. 80 (4): 1959–64. doi:10.1128/JVI.80.4.1959-1964.2006. PMC 1367171. PMID 16439551.
- ^ "NIAID Taps Chiron to Develop Vaccine Against H9N2 Avian Influenza". National Institute of Allergy and Infectious Diseases (NIAID). 2004-08-17. Retrieved 2010-01-31.
- ^ Rapanan JL, Cooper KE, Leyva KJ, Hull EE (August 2014). "Collective cell migration of primary zebrafish keratocytes". Experimental Cell Research. 326 (1): 155–65. doi:10.1016/j.yexcr.2014.06.011. PMID 24973510.
- ^ Lee J, Jacobson K (November 1997). "The composition and dynamics of cell-substratum adhesions in locomoting fish keratocytes". Journal of Cell Science. 110 ( Pt 22): 2833–44. PMID 9427291.
- ^ Hunt P, Robertson D, Weiss D, Rennick D, Lee F, Witte ON (March 1987). "A single bone marrow-derived stromal cell type supports the in vitro growth of early lymphoid and myeloid cells". Cell. 48 (6): 997–1007. doi:10.1016/0092-8674(87)90708-2. PMID 2435412. S2CID 31499611.
- ^ van den Berg-Bakker CA, Hagemeijer A, Franken-Postma EM, Smit VT, Kuppen PJ, van Ravenswaay Claasen HH, et al. (February 1993). "Establishment and characterization of 7 ovarian carcinoma cell lines and one granulosa tumor cell line: growth features and cytogenetics". International Journal of Cancer. 53 (4): 613–20. doi:10.1002/ijc.2910530415. PMID 8436435.
- ^ Lee YG, Korenchuk S, Lehr J, Whitney S, Vessela R, Pienta KJ (2001). "Establishment and characterization of a new human prostatic cancer cell line: DuCaP". In Vivo. 15 (2): 157–62. PMID 11317521.
- ^ Ou D, Mitchell LA, Décarie D, Tingle AJ, Nepom GT (March 1998). "Promiscuous T-cell recognition of a rubella capsid protein epitope restricted by DRB1*0403 and DRB1*0901 molecules sharing an HLA DR supertype". Human Immunology. 59 (3): 149–57. doi:10.1016/S0198-8859(98)00006-8. PMID 9548074.
Further reading
- Pacey L, Stead S, Gleave J, Tomczyk K, Doering L (2006). "Neural Stem Cell Culture: Neurosphere generation, microscopical analysis and cryopreservation". Protocol Exchange. doi:10.1038/nprot.2006.215.
- Gilabert JA, Montalvo GB, Artalejo AR (2006). "Rat Chromaffin cells primary cultures: Standardization and quality assessment for single-cell assays". Protocol Exchange. doi:10.1038/nprot.2006.294.
- Losardo RJ, Cruz-Gutiérrez R, Prates JC, Moscovici M, Rodríguez-Torres A, Arteaga-Martinez M (2015). "Sergey Fedoroff: A Pioneer of the Neuronal Regeneration. Tribute from the Pan American Association of Anatomy". International Journal of Morphology. 33 (2): 794. doi:10.4067/S0717-95022015000200059.
- MacLeod RA, Dirks WG, Matsuo Y, Kaufmann M, Milch H, Drexler HG (November 1999). "Widespread intraspecies cross-contamination of human tumor cell lines arising at source". International Journal of Cancer. 83 (4): 555–63. doi:10.1002/(SICI)1097-0215(19991112)83:4<555::AID-IJC19>3.0.CO;2-2. PMID 10508494.
- Masters JR (April 2002). "HeLa cells 50 years on: the good, the bad and the ugly". Nature Reviews. Cancer. 2 (4): 315–9. doi:10.1038/nrc775. PMID 12001993. S2CID 991019.
- Witkowski JA (July 1983). "Experimental pathology and the origins of tissue culture: Leo Loeb's contribution". Medical History. 27 (3): 269–88. doi:10.1017/S0025727300042964. PMC 1139336. PMID 6353093.
External links
- Table of common cell lines from Alberts 4th ed.
- Cancer Cells in Culture
- Evolution of Cell Culture Surfaces
- Hypertext version of the Cell Line Data Base
- Microcarrier Cell Culture Handbook by GE Healthcare Life Sciences
- Cell Culture Applications - Resources including application notes and protocols to create an ideal environment for growing cells, right from the start.
- Cell Culture Basics - Introduction to cell culture, covering topics such as laboratory set-up, safety and aseptic technique including basic cell culture protocols and video training
- Database of Who's Who in Cell Culture and Related Research
- Coriell Cell Repositories
- Strategies for Protein Purification Handbook
- An Introduction To Cell Culture. This webinar introduces the history, theory, basic techniques, and potential pit-falls of mammalian cell culture.
- The National Centre for Cell Science (NCCS), Pune, India; national repository for cell lines/hybridomas etc.
- Public Health England, Public Health England Culture Collections (ECACC)


